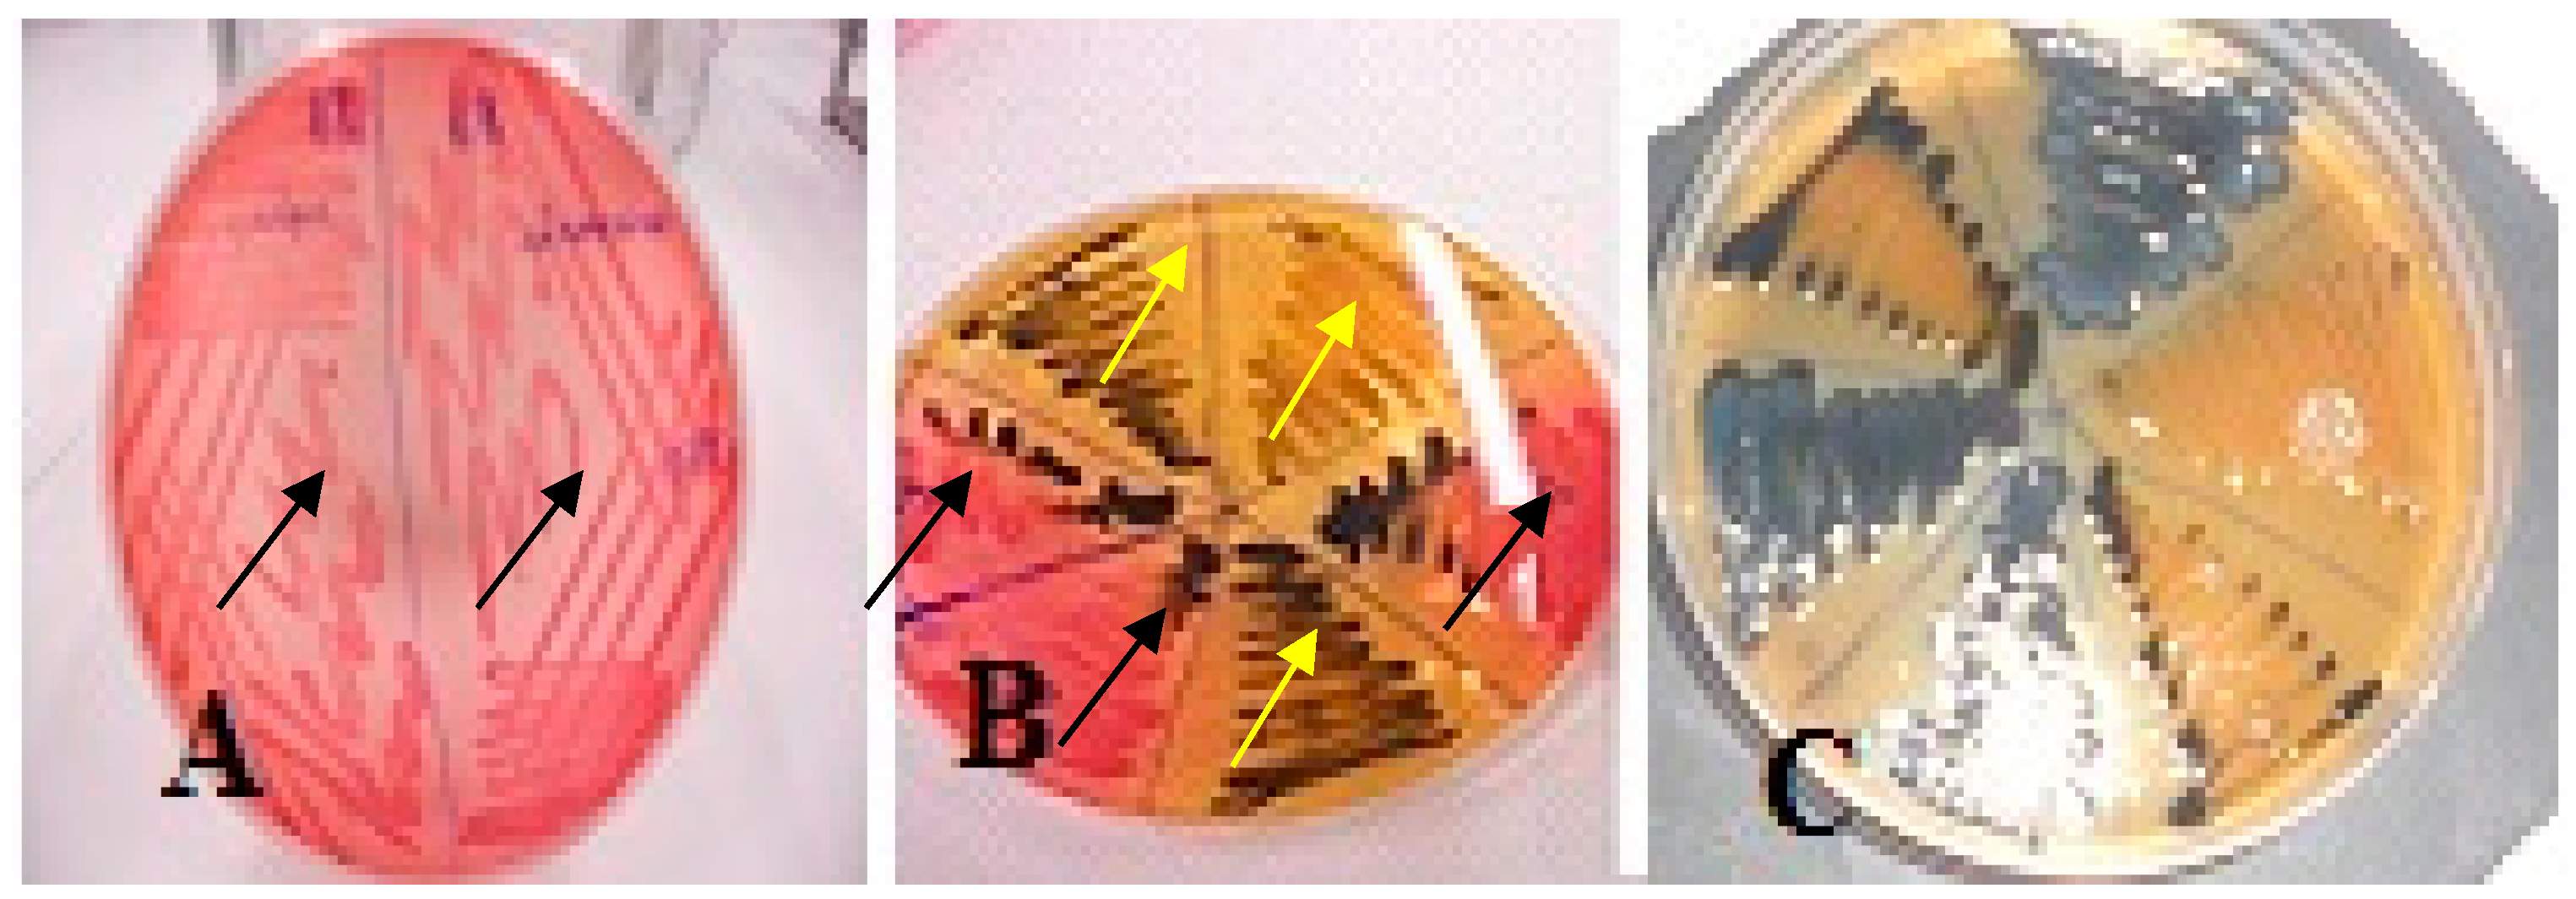
Applsci 14 00953 g002

Abstract
The objective of the present report is the dissemination of information acquired during the application of ISO 6579-1:2017 for the isolation of Salmonella spp. from swine samples. ISO 6579-1:2017 is the protocol officially recommended by the EU for the isolation of Salmonella spp., aiming for the harmonization of effective control of Salmonella infection in food-producing animals. Successful control of animal salmonellosis is highly dependent on the sensitivity and reliability of the biochemical methods used to detect the presence of the pathogen in various stages of food production. Application of ISO 6579-1:2017 resulted in the isolation of twelve Salmonella spp. and eighteen other members of the family of Enterobacteriaceae biochemically and other bacteria antigenically resembling salmonellae. An evaluation of the culture media was conducted, including xylose-lysine-desoxycholate agar (XLD), Salmonella–Shigella Agar (SS), Brilliant Green Agar (BGA), Salmonella Chromogenic Agar (SCA), Triple Sugar Iron (TSI), and modified semi-solid Rappaport–Vassiliadis (MSRV) agar. The evaluation showed that these culture-selective media differed significantly in their performance for the isolation of Salmonella from swine samples. It was concluded that the presence of atypical Salmonella strains negatively affects the prevalence of Salmonella, thus affecting the identification of carrier pigs and eventually affecting the efficiency of control programs. Thus, doubtful results require additional biochemical testing to confirm the accuracy of such universally recommended isolation methods.
Keywords:
Salmonella; isolation; ISO 6579-1:2017; pre-enrichment; selective media; culture methods; swine 1. Introduction
Salmonella spp. are the most prevalent species of pathogens implicated in food-borne infections [1,2]. Thus, their monitoring and control in animals across the EU is a priority. Pigs are an important source of human infection with Salmonella spp. [3,4],;hence, pig farms are targets for the control of the pathogen. Its effective control depends on the accurate estimation of Salmonella prevalence in a pig population, which depends on the sampling plans, sample points (surfaces of the slaughterhouse or part of the pork tested for presence of Salmonella), and number of grams/surface area tested; thus, isolation of the agent [5,6] uses a combination of culture media. Some of them are, due to their selectivity and sensitivity, the ‘gold standard’ for Salmonella isolation. However, for ensuring protection of the public, a combination of methods is recommended by accreditation bodies and regulatory authorities, such as the International Standards Organization (ISO). Salmonella spp. are a genus requiring more techniques and methods for isolation and identification of its members than most other agents of public health importance [7]. The complexity of the investigation of animal salmonellosis demanded a universally applied methodology for the isolation of Salmonella spp. from animals and their products across the EU. This methodology is described in EN-ISO 6579-1:2017 [8], which has become the reference method for assessing the prevalence of Salmonella spp. infection in fattening and breeding pigs [9,10,11]. The EN-ISO 6579 has been found to perform better than commercial polymerase chain reaction (PCR), the BAX method (a real time PCR assay,) and three other commercially available systems based on enzyme-linked immunosorbent assay [12]. The use of this ISO, although expensive and laborious, is considered a 100% specific method when used in combination with serotyping [13]. As a universally used method, it also helps the comparison of results across the EU and thus the coordination of control programs undertaken in various member states.
The newer version, ISO 6579-1:2017, provides guidance for primary sampling methods and the preparation of samples before isolation, but also for strain identification for a detailed epidemiological investigation. Salmonella spp. are isolated after pre-enrichment in buffered peptone water (BPW), resuscitating sub-lethally damaged or slow-growing Salmonella cells, thus minimizing false-negative results. Pre-enrichment also helps the pathogen to survive the toxic effects of selective enrichment media [14,15] when it is present in very low numbers, as is the case with asymptomatic animals. However, pre-enrichment may not help with isolation from feces of the less vigorous Salmonella strains, such as the host-adapted ones. The problem in this case is the overgrowth of competing bacteria species multiplying faster than slow-growing Salmonella during non-selective pre-enrichment [16]. When such a case is suspected, enrichment on modified semi-solid Rappaport–Vassiliadis (MSRV) medium supplemented with novobiocin is recommended. MSRV medium supplemented with novobiocin inhibits the growth of most Gram-positive and negative bacteria, helping with the growth of less vigorous Salmonella spp. The introduction of this medium improved recovery compared to previously used selective enrichment broths, such as Rappaport–Vassiliadis (soya base) (RVS) broth [17]. In addition, direct visualization of cultures minimizes time and material for confirming a definite negative result [18,19,20,21]. In all other cases, pre-enrichment is followed by enrichment using selective plating on xylose-lysine-deoxycholate (XLD) agar and is supplemented by an additional agar medium of choice, which enhances the differentiation of salmonellae from other enterobacteria. This media combination, which inhibits the growth of bacteria other than Salmonella, also gives important information on some principal differential biochemical characteristics, such as non-lactose fermentation and hydrogen sulfide (H2S) production [22]. Exceptions are Proteus, Pseudomonas, Citrobacter, and Hafnia [23,24] species resembling Salmonella spp., and also S. arizonae and S. diarizonae, that ferment lactose or variably produce H2S. False-negative cultures may also occur if the low number of Salmonella bacteria present in a sample is suppressed by the overgrowth of other bacteria. Thus, the quality of a sample, culture medium selectivity, and also the incubation conditions affecting, perhaps, the expression of certain biochemical characteristics, influence prevalence.
In order to minimize workloads and false results, many chromogenic agars have been developed to aid with the differentiation of suspect colonies [22,25,26]. Generally, chromogenic agars contain a combination of chromogenic substrates metabolized only by the targeted bacteria species, which produce colonies of distinctive coloring [27]. They are, however, serovar-dependent, thus frequently leading to false results [28] and they are also relatively expensive, increasing the costs of routine laboratory procedures for animal testing [29]. In addition, the development of culture media promising increased sensitivity and specificity increases inter-laboratory inconsistency if standard procedures are not applied [30].
The various serological, biochemical and molecular tests applied require 5–11 days for a definitive confirmation of a suspect isolate [8]. Salmonella spp. are generally considered to be non-lactose-fermenting (NLFs); Gram-negative rods; motile due to peritrichous flagellae (excluding serovars Pullorum and Gallinarum); glucose fermenting, with the production of acid and usually gas; positive to catalase, methyl red and Simmons citrate reaction; and negative to urease, lysine decarboxylase, indole, oxidase, and Voges Proskauer (VP) tests. They produce H2S and ferment L-arabinose, maltose, D-mannitol, D-mannose, L-rhamnose, D-sorbitol (except ssp VI), trehalose, D-xylose, and dulcitol. These tests are now available in commercial identification kits, such as the API 20E (BioMιrieux) or the MicrogenTM GnA+B-ID (Microgen Bioproducts Ltd., Camberley, Surrey, UK) systems. The small amounts of media used in these systems reduce both cost and workload. Once a strain is identified as possibly belonging to Salmonella spp., this requires confirmation by serological testing for the detection of somatic (O), flagellar (H), and virulence (Vi) antigens possessed by salmonellae. However, accurate identification of a serovar is possible when the Kauffman–White Scheme is performed in a Salmonellae reference laboratory where, in the case of doubtful results, phage typing and a genetic profile can be also obtained by experienced microbiologists using the most appropriate culture methodology and media.
In consideration of the above, the objective of the present reporting is the dissemination of knowledge acquired from the observations and diagnostic difficulties resolved using the culture methods recommended by ISO 6579-1:2017 for the isolation of Salmonella spp. from swine samples collected at slaughter.
2. Materials and Methods
Samples, Isolation, and Serotyping of Salmonella spp.
The observations reported refer to the testing of 615 tissue samples collected at slaughter from 123 randomly selected healthy pigs of 15 farrow-to-finish herds in Central Greece. Samples were collected after evisceration from the colon, ileum, mesenteric lymph nodes, gall-bladder, and muscle tissue from the pigs’ neck.
Isolation and typing procedures followed the Salmonella ISO 6579-1:2017 for food and animal feeding stuffs, as described elsewhere [31]. Suspect colonies were subcultured on Columbia blood agar (Oxoid, Basingstoke, UK) and examined with Gram stain, and if they were Gram-negative rods they were tested for oxidase production, utilization of Triple Sugar Iron Agar (Merck-Germany, Darmstadt, Germany), and colony appearance on Salmonella Chromogenic Agar (SCA-Biolife-Italy, Milan, Italy). Salmonella-suspect colonies showed magenta coloring on the SCA after 18 to 24 h of incubation, while colonies of other members of the family Enterobacteriaceae appeared as blue or uncolored. Suspect colonies were assigned to species using the API 20E (Biomerieux, Craponne, France) and the MicrogenTM GnA+B-ID (Microgen Bioproducts Ltd., Camberley, UK) systems recommended for Gram (−) bacteria. Isolates identified as Salmonella spp. were tested with a polyvalent slide agglutination test (Remel Europe Ltd., Dartford, UK) detecting O- and H- antigens, and positive samples were sent to the Greek National Reference Laboratory (GNRL) for specific serotyping. All lactose-positive and H2S-negative isolates identified as Salmonella spp. were subcultured on Salmonella–Shigella (SS) agar side by side with lactose-negative-H2S-positive isolates.
Additionally, the swab sample and a loopful of BPW culture from the same sample were directly inoculated onto XLD medium, bypassing the pre-enrichment and enrichment stages.
3. Results
The GNRL recognized isolated Salmonella spp. as belonging to fourteen serovars. These were S. Typhimurium (21 isolates), S. enterica subsp. enterica ser. 4,12:i:- (9 isolates), S. enterica subsp. enterica. 6,7:k:- (7 isolates), S. enterica subsp. enterica ser. 4,5,12:i:- (6 isolates), S. Bredeney (3 isolates), and one each of S. Agona, S. Derby, S. Infantis, S. Meleagridis, S. Cerro, S. enterica subsp. enterica ser. 6,14,25:-:1,2, S. enterica subsp. diarizonae 61:k:1,5, S. enterica subsp. salamae 38:b:1,2, and S. enterica subsp. houtenae 40:g,t:-. Four isolates were reported as ‘Rough strains’.
Except for two isolates, S. enterica subsp. enterica ser. 4,5,12:i:- and S. enterica subsp. enterica ser. 6,14,25:-:1,2, which had been isolated without enrichment (directly cultured from pre-enrichment on XLD), all others were isolated after enrichment.
3.1. Phenotypic Expression of Salmonella Isolates on Selective Media
The phenotypic expression of Salmonella colonies on selected culture media are presented in Table 1. The accepted colony appearances for the various media used after incubation for 18 to 48 h are: magenta colonies on SCA, transparent colonies with or without black centers on SS, transparent colonies with or without black centers on XLD, and transparent colonies on BGA.

Table 1.
Atypical Salmonella isolates.
Fifty six (94.92%) of the 59 Salmonella isolates transferred from MSRV to SCA medium and incubated for 24 h produced magenta colonies and forty seven (79.66%) appeared as characteristic black colonies on XLD, SS, and BG media due to production of H2S. S. enterica subsp. enterica ser. 6,14,25:-:1,2, S. enterica subsp. houtenae 40:g,t:-, and S. enterica subsp. salamae 38:b:1,2 appeared as transparent colonies on SCA medium (Figure 1) and as transparent colonies surrounded by yellow halos on XLD medium, without black centers. The same serovars appeared on SS agar as red colonies (lactose-positive) without black centers. Interestingly, when they were co-cultured with Salmonella isolates of typical appearance on SS media, they progressively (in 30 h) exhibited characteristics of H2S production and appeared as yellow colonies (lactose-negative), giving a delayed expression of typical Salmonella spp. (Figure 2 and Figure 3). The above isolate produced yellow to greenish-yellow colonies on BG agar, which converted to red-colored colonies and red medium when co-cultured with Salmonella isolates of typical colony coloring. TSI testing showed a delayed reaction giving a yellow butt/slant and H2S production in 24 h that changed to a typical red after 48 h of incubation. The above rare isolates showed very poor growth on MSRV compared to typical salmonellae. However, they agglutinated with the polyvalent antisera and their biochemical profiles (micro kits) were ‘Salmonella spp.’. The phenotypical profile described above was the same for two S. enterica subsp. enterica. 6,7:k:- isolates, which developed the characteristic agenta colonies on SCA, although one had been identified by both the API and Microgen systems as ‘E. coli’.

Figure 1.
Transparent colonies of S. enterica subsp. houtenae 40:g,t:- (left) and typical magenta colonies of S. Typhimurium (right) on SCA.

Figure 2.
(A) Lactose-positive-H2S (−) Salmonella isolates on SS agar after 24 h. (B,C) Lactose-positive Salmonella isolates (black arrows) co-cultured with typical Salmonella isolates (yellow arrows) after 30 h and after 48 h, respectively.

Figure 3.
Typical Salmonella isolate (red arrows) on SS (a) and TSI (b) media co-cultured with (i) Salmonella H2S (−) (strains 17, 50/yellow arrows) and (ii) E.coli (strains 30, 113/green arrows) after 36 h incubation.
Three strains of S. enterica subsp. enterica ser. 4,12:i:- serovar and one of S. enterica subsp. enterica ser. 4,5,12:i:-, produced characteristic Salmonella colonies on SCA, SS, and BG agars, but they appeared as pink transparent colonies with a large skirt and a very small black center like a ‘pinhead’ on XLD. The first three strains had a typical reaction when tested on TSI medium, while the last gave a yellow butt/slant and very little H2S production, also showing weak growth on MSRV compared to the other three strains.
S. Cerro and S. enterica subsp. diarizonae 61:k:1,5 produced characteristic colonies on SCA and BG, but on XLD they produced transparent colonies without black centers and a red media. They also produced lactose-negative (yellow) colonies with or without black centers on SS agar. S. Cerro gave a yellow butt/slant on TSI agar with very little H2S production. Interestingly, its biochemical profile given by MicrogenTMGnA+B-ID was ‘inactive E. coli’. S. enterica subsp. diarizonae 61:k:1,5 gave a red butt/yellow slant and very little H2S production on TSI. Both isolates showed weak growth on MSRV but strong agglutination with the polyvalent antisera.
Finally, of the 615 samples cultured on MSRV 59 that had no growth, 47 (7.64%) showed very strong growth (inoculated plates turned to white due to swarming) indicative of Salmonella spp. and 509 samples (82.76%) produced only zones of turbidity (Figure 4).

Figure 4.
(A) E. coli on MSRV; the medium does not inhibit the growth of the microorganism. (Β) Salmonella spp. on MSRV; the medium has a whitish color.
3.2. Phenotypic Appearance of Gram-Negative Isolates Other than Salmonella spp. on Salmonella-Selective Media
ISO 6579:2017 permitted the growth of eighteen Gram-negative isolates that resembled Salmonella spp. (transparent and/or black colonies on the selective media) that were eventually identified as Escherichia coli (12 isolates), Citrobacter freundii (3 isolates), Trabulsiella guamensis (2 isolates), and Klebsiella ozanae (1 isolate). These showed little to very good growth on MSRV agar (Table 2).

Table 2.
Enterobacteriaceae resembling Salmonella: color of colony and media utilization.
Specifically, E. coli isolates produced pink transparent colonies with or without ‘pinhead’ black centers on XLD and transparent colorless colonies on SCA. Ten of them produced yellowish colonies on BG and red (lactose-positive) colonies on SS. When they were co-cultured with typical Salmonella spp. isolates, they showed evidence of H2S production and changed to yellow colonies (lactose-negative) after 48 h of incubation. The remaining two produced lactose-negative colonies on SS agar with small black centers and transparent colonies with red media on BG. Ten of the twelve showed yellow butt/red slant on TSI agar and eight (8) produced H2S. The remaining two produced yellow butt/yellow slant/H2S (+) (Figure 3). Interestingly, seven of them agglutinated partially or totally with the polyvalent Salmonella antisera.
Two of the C. freundii isolates produced pink transparent colonies with black centers on XLD, while the third produced yellow colonies with black centers. Two of them produced lactose-positive (red) colonies on SS agar and one produced lactose-negative colonies with a black center. All of them showed colorless colonies on SCA and yellowish colonies on BG agar. They had yellow butt/red slant/H2S (+) on TSI agar and gave slight agglutination with the polyvalent Salmonella antisera. Two of them were indole negative.
One of the T. guamensis isolates resembled Salmonella on all of the media that were evaluated and gave light agglutination with the polyvalent Salmonella antisera but was indole positive. The other produced yellow colonies with black centers on XLD. It did not agglutinate with the polyvalent O antisera, but it gave a very light positive reaction when tested with the polyvalent H antisera.
K. ozanae exhibited yellow colonies with small black centers on XLD, blue colonies on SCA, lactose-negative colonies with large black centers on SS agar, and transparent colonies on BG and gave a yellow butt/slant and a ‘trace’ of H2S production on TSI.
4. Discussion
A wide range of methodologies are available for the bacteriological isolation and characterization of Salmonella, which demands the harmonization of results across the EU member states for Salmonella surveys and enforcement of regulations. This harmonization was enforced by the mandatory use of ISO 6579-1:2017. However, our observations show that the efficacy of the ISO needs further validation. Such problems with existing bacteriological methods and the need for faster reliable results promote research into the development of molecular methods. However, for fecal and environmental samples derived from pigs, molecular methods are still in the early stages of development with regard to giving consistent results. For now, the adoption of new methods in routine laboratory monitoring control programs is a compromise between improved sensitivity, specificity and selectivity, speed, ease of use, and economic benefits. However, compromise may result in the loss of some ‘exotic’ Salmonella serovars, negatively affecting their prevalence and eventually the effectiveness of control programs.
Thus, the growing availability of studies held periodically to determine the sensitivity of the various new culture media show that some perform better than others. Their performance is, perhaps, influenced by the kind of sample (e.g., food, feed, feces, environmental sources) or the species of the pathogen [32] infecting swine, with no culture method likely to be safely reliable in recovering all serovars [33,34,35,36,37,38,39,40]. Hence, recovery of Salmonella spp. from swine samples can be significantly different between culturing methods, with MSRV used for enrichment of swine feces improving recovery because it inhibits growth of most fecal bacteria species, increasing in this way the sensitivity of XLD and BGA agars [12,20,36]. Their sensitivity after the use of MSRV is increased to 96% (in naturally contaminated food samples) compared to the standard methods [41].
In the present work, 47 (7.64%) of 615 samples cultured on MSRV showed extensive swarming indicative of Salmonella’s migration through the MSRV medium and expressed as turbidity (whitening of the medium). Unfortunately, of the 509 samples producing minimal turbidity, nine (9) were eventually identified as Salmonella, a number reducing the specificity of MSRV for Salmonella spp., which proved to be very poor for this specific medium (81.3% false positive results on the factor of inhibiting growth of non-Salmonella species). The reduction of specificity necessitates complementary testing, increasing labor and costs, in order to differentiate salmonellae from other microorganisms. Perhaps, pre-enrichment needs optimization according to a sample’s suspected microbial burden, which may also help the recovery of damaged or slow-growing Salmonella.
Of interest was also the direct recovery of three Salmonella isolates from non-selective pre-enrichment broth. These isolates had been lost on enrichment media (MSRV) as their inability to grow on this medium was confirmed. MSRV medium had, perhaps, a killing effect on this isolates that affected the prevalence of Salmonella spp. in an animal population or food stuff. This finding implies that maximum detection can result from the combination of selective enrichment and direct plating from pre-enrichment media. This is, however, unacceptable for routine testing when large numbers of samples are tested.
It was also evident that the choice of differential plating culture media significantly affects recovery. This study confirmed that most but not all Salmonella serovars grow adequately on XLD, SS, BG, and SCA. With the exception of the three rare Salmonella serovars, SCA appeared as a medium with better specificity than the combination of XLD, SS, BGA, and TSI. Similar problems of non-specific and difficult to interpret results recorded here during the use of the former version, ISO 6579:2002/Amd 1:2007 (Annex D) have been previously reported [22], and show that false positives (e.g., Citrobacter, Proteus) increase the workload and costs of a control program.
A previous comparison between XLD and BGA media showed that BGA is inferior to XLD due to its higher selectivity [42,43], and the same was observed in the present study. Although the use of chromogenic media makes the recognition of most salmonellae easier, the present study showed that they fail in cases with rarer Salmonella serovars. These serovars could come to be of epidemiological importance in later times if they are not accounted during control programs. Thus, failure of culture methods to recognize some Salmonella serovars leads to a false assessment of the infectiousness of a given sample [40]. The suppression of competing bacteria in the original sample to allow the growth of Salmonella to the level of detection is important, but it may also affect sensitivity of the conventional culturing media used. Sensitivity could be improved with the use of multiple culturing methods in parallel, but the combination increases workload and costs.
Of interest was also the detection of lactose-positive Salmonella isolates resembling E. coli on XLD and SS agars. Lactose fermentation is a biochemical test differentiating Salmonella from other Enterobacteriaceae. Since 1887, E. coli has been recognized as a lactose fermenter and Salmonella as a non-lactose fermenter. Therefore, this information was used for the development of the differential agar media XLD, SS, and BG. However, a few decades ago Ewing (1986) [44] reported that about 1% of all salmonellae ferment lactose, but the true incidence of lactose-fermenting (lac+) salmonellae is yet unknown, because most diagnostic laboratories do not further characterize lactose-positive colonies [45]. Lac+ Salmonella strains of some important serovars, such as serovar Typhimurium, have been reported [46,47,48] from animal populations, and it is important for these to be accounted for during the application of control programs or during the investigation of suspect food-borne human cases.
The types of colonies examined here would not have been selected for further testing if the ISO was strictly followed because they resembled typical lac+ E. coli. This would have resulted in their underreporting. False-negative samples may also occur if Salmonella lac+ strains are masked by the growth of bacteria, such as Klebsiella spp., which carry the lactose (lac) operon on a plasmid or a chromosome [49,50].
Another important taxonomic characteristic of Enterobacteriaceae is the production of H2S. Citrobacter, Proteus, and Salmonella are major H2S-producing genera. H2S production is, perhaps, helping the colonization of gut and, in synergy with other virulence determinants, the development of gastroenteritis [51]. About 97% of Salmonella spp., with the exception of S. Choleraesuis and S. Typhi [52], produce H2S. However, this characteristic may be absent in environmental strains of Salmonella spp. due to mutations [53,54]. One pathway of H2S production is through the reduction of thiosulfate mediated by enzymethiosulfate reductase [51,55,56]. However, there are some problems in the interpretation of H2S production needing further consideration. Specifically:
- (i)
- The content and availability of the sulfur source and peptones of the culture media. Peptones themselves contain varying amounts of sulfur amino acids and partially oxidized sulfur compounds, potentially giving a false positive result.
- (ii)
- The commercial diagnostic media may also contain fermentable carbohydrates, resulting in the masking of H2S production by the production of acid during sugar fermentation either because it is repressed or because it cannot be detected.
- (iii)
- The ability of the microorganism to stimulate H2S-producing enzymes and its H2S-producing rate [51,55,57]. Some consider that the ability of an isolate to produce H2S is plasmid mediated [58,59,60,61,62], although the nature of the plasmid differs from isolate to isolate. This could be the reason that lactose-positive Salmonella spp. appeared giving negative (−) H2S production on XLD and SS agars, possibly influenced by fermentation [63]. In the present study, non-H2S-producing Salmonella and E. coli isolates were stimulated to produce H2S when cultured side by side with H2S-producing isolates. Perhaps, the ‘masking’ of H2S was overcome in synergy when lactose-negative and strong H2S-producing isolates were cultured side by side. However, false-negative results decrease the recovery of Salmonella spp. if ISO recommendations are strictly followed, which influences its diagnostic value.
Of similar diagnostic importance is the isolation of E. coli strains producing H2S and resembling Salmonella on XLD. The inability of E. coli to produce detectable amounts of H2S on recommended culture media is a differential characteristic of the genus Escherichia, although H2S-producing variants have been isolated on numerous occasions [59,60,62,64,65,66]. Researchers suggest that the ability of E. coli to produce H2S is transferable between microorganisms in a similar way to the transfer of hemolysins, colicins, and plasmids for drug resistance and enterotoxin [60]. Although the isolation of H2S-producing variants of E. coli is infrequent [59] and their clinical significance remains unclear, their presence in specimens influences the diagnostic process due to misclassification. As for the role of H2S-producing microorganisms in the gut, one could think that they may synergistically reactivate the ‘masked’ ability of H2S-producing Salmonella spp., with the abundance of E. coli in the gut increasing their virulence.
Additionally, such diagnostic problems could negatively affect national schemes for controlling Salmonella infections in animals in order to protect the consumer. Surveillance of Salmonella in all stages of the food chain is important in the epidemiology of food-borne salmonellosis and thus the development and successful implementation of control strategies. Their success is largely dependent on reliable laboratory methods for the isolation, identification, and typing of suspect colonies. Diagnostic laboratories must choose isolation and identification approaches that efficiently provide accurate results that are comparable between laboratories. The development of standard culture methods, as described by ISO 6579-1:2017, and the participation in proficiency quality assurance programs helps with harmonization between laboratories. However, there is not a single method that fulfils all criteria or is optimal for all purposes, and in some cases complementary biochemical tests are necessary. Recognizing the limits of the currently used selective and differential media is helping the improvement of their specificity and sensitivity and therefore the differentiation of Salmonella spp. from other Enterobacteriaceae sharing common biochemical and antigenic characteristics, while retaining cost-effectiveness. Reliability, ease of use, and costs are characterizing conventional selective and differential media as compared to the newer chromogenic ones not yet established. The use of two conventional selective media with different selective and differentiating properties in conjunction with the experience of the bench technician is likely to help with the detection of atypical strains, like the lactose-fermenting strains, which in most cases are discarded as they are not considered important. The objective should always be to maximize detection of major zoonotic Salmonella strains [67]. Thus, the working protocol should aim toward this objective, which will be further achieved if the microbiologist is scientifically prepared to detect those strains considered “rarer”. These rarer ones, perhaps, of little epidemiological importance today, could become a potential threat in the future. Failure to recognize atypical strains of Salmonella spp. could result in considerable epidemiological problems in later years.
Author Contributions
Conceptualization, G.E. and A.R.B.; methodology, G.E. and A.R.B.; investigation, G.E. and A.R.B.; writing—original draft preparation, G.E. and A.R.B.; software, N.S.; resources, N.S.; supervision, N.S. All authors have read and agreed to the published version of the manuscript.
Funding
This research received no external funding.
Institutional Review Board Statement
Not applicable.
Informed Consent Statement
Not applicable.
Data Availability Statement
Data is contained within the article.
Conflicts of Interest
The authors declare no conflicts of interest.
References
- Majowicz, S.E.; Musto, J.; Scallan, E.; Angulo, F.J.; Kirk, M.; O’Brien, S.J.; Jones, T.F.; Fazil, A.; Hoekstra, R.M. The global burden of nontyphoidal Salmonella gastroenteritis. Clin. Infect. Dis. 2010, 50, 882–889. [Google Scholar] [CrossRef] [PubMed]
- 2. EFSA and ECDC (European Food Safety Authority and European Centre for Disease Prevention and Control). The European Union One Health 2021 Zoonoses Report. EFSA J. 2022, 20, e07666. [Google Scholar] [CrossRef]
- Pires, S.M.; de Knegt, L.; Hald, T. Estimation of the Relative Contribution of Different Food and Animal Sources to Human Salmonella Infections in the European Union; Scientific/Technical Report; European Food Safety Authority: Parma, Italy, 2011. [Google Scholar]
- Chaname Pinedo, L.; Mughini-Gras, L.; Franz, E.; Hald, T.; Pires, S.M. Sources and trends of human salmonellosis in Europe, 2015–2019: An analysis of outbreak data. Int. J. Food Microbiol. 2022, 379, 109850. [Google Scholar] [CrossRef] [PubMed]
- Alocilja, E.C.; Radke, S.M. Market analysis of biosensors for food safety. Biosens. Bioelectron. 2003, 18, 841–846. [Google Scholar] [CrossRef]
- Hurd, H.S.; McKean, J.D.; Griffith, R.D.; Rostagno, M.H. Estimation of the Salmonella enterica prevalence in finishing swine. Epidemiol. Infect. 2004, 132, 127–135. [Google Scholar] [CrossRef]
- Waltman, W.D.; Mallinson, E.T. Isolation of Salmonella from poultry tissue and environmental samples: A nationwide survey. Avian Dis. 1995, 39, 45–54. [Google Scholar] [CrossRef]
- ISO 6579-1:2017; Microbiology of the Food Chain—Horizontal Method for the Detection, Enumeration and Serotyping of Salmonella—Part 1: Detection of Salmonella spp. ISO (International Organization for Standardization): Geneva, Switzerland, 2017.
- European Food Safety Authority. Report of the Task Force on Zoonoses Data Collection on the analysis of the baseline survey on the prevalence of Salmonella in slaughter pigs, in the EU, 2006-2007. Part A. Salmonella prevalence estimates. EFSA J. 2008, 135, 1–111. [Google Scholar]
- European Food Safety Authority. Analysis of the baseline survey onthe prevalence of Salmonella in holdings with breeding pigs in the EU, 2008. Part A. Salmonella prevalence estimates. EFSA J. 2009, 7, 1–93. [Google Scholar]
- EFSA (European Food Safety Authority); Boelaert, F.; Papanikolaou, A.; Rizzi, V.; Stoicescu, A.-V. Manual for Reporting on Zoonoses and Zoonotic Agents, within the Framework of Directive 2003/99/EC, and on Some Other Pathogenic Microbiological Agents for Information Derived from the Year 2019; EN-1791; EFSA Supporting Publication: Parma, Italy, 2020; p. 63. [Google Scholar] [CrossRef]
- Eriksson, E.; Aspan, A. Comparison of culture, ELISA and PCR techniques for Salmonella detection in faecal samples for cattle, pig and poultry. BMC Vet. Res. 2007, 3, 21. [Google Scholar] [CrossRef]
- ISO 6579:2002/Amd 1:2007; Detection of Salmonella spp. in Animal Faeces and in Environmental Samples from the Primary Production Stage, Amendment 1, Annex D. In Microbiology of Food and Animal Feeding Stuffs. Horizontal Method for the Detection of Salmonella spp. International Organization for Standardization: Geneva, Switzerland, 2007.
- Baylis, C.L.; MacPhee, S.; Betts, R.P. Comparison of two commercial preparations of buffered peptone water for the recovery and growth of Salmonella bacteria from foods. J. Appl. Microbiol. 2000, 89, 501–510. [Google Scholar] [CrossRef]
- Zheng, Q.; Mikš-Krajnik, M.; D’Souza, C.; Yang, Y.; Heo, D.-J.; Kim, S.-K.; Lee, S.-C.; Yuk, H.-G. Growth of healthy and sanitizer-injured Salmonella cells on mug bean sprouts in different commercial enrichment broths. Food Microbiol. 2015, 52, 159–168. [Google Scholar] [CrossRef] [PubMed]
- Gracias, K.S.; McKillip, J.L. A review of conventional detection and enumeration methods for pathogenic bacteria in food. Can. J. Microbiol. 2004, 50, 883–890. [Google Scholar] [CrossRef] [PubMed]
- Zdragas, A.; Tsakos, P.; Mavrogeni, P. Evaluation of two assays, MSRV and RV, for the isolation of Salmonella spp. from wastewater samples and broiler chickens. Lett. Appl. Microbiol. 2000, 31, 328–331. [Google Scholar] [CrossRef] [PubMed]
- Read, S.C.; Irwin, R.J.; Poppe, C.; Harris, J. A comparison of two methods for isolation of Salmonella from poultry litter samples. Poult. Sci. 1994, 73, 1617–1621. [Google Scholar] [CrossRef] [PubMed]
- Davies, R.H.; Wray, C. Evaluation of a rapid cultural method for identification of salmonellas in naturally contaminated veterinary samples. J. Appl. Bacteriol. 1994, 77, 237–241. [Google Scholar] [CrossRef] [PubMed]
- Voogt, N.; Raes, M.; Wannet, W.J.; Henken, A.M.; van de Giessen, A.M. Comparison of selective enrichment media for the detection of Salmonella in poultry faeces. Lett. Appl. Microbiol. 2001, 32, 89–92. [Google Scholar] [CrossRef] [PubMed]
- Dam-Deisz, W.D.; Maas, H.M.; Nagelkerke, N.; van de Giessen, A.W. Comparison of selective enrichment media for the isolation of Salmonella spp. from faecal samples from fattening pigs, veal calves and dairy cows. De Ware(n) Chem. 2003, 3, 143–151. [Google Scholar]
- Manafi, M. New developments in chromogenic and fluorogenic culture media. Int. J. Food Microbiol. 2000, 60, 205–218. [Google Scholar] [CrossRef]
- Tate, C.R.; Miller, R.G.; Mallinson, E.T.; Douglass, L.W.; Johnston, R.W. The isolation of salmonellae from poultry environmental samples by several enrichment procedures using plating media with and without novobiocin. Poult. Sci. 1990, 69, 721–726. [Google Scholar] [CrossRef]
- Eigner, U.; Reissbrodt, R.; Hammann, R.; Fahr, A.M. Evaluation of a new chromogenic medium for the isolation and presumptive identification of Salmonella species from stool specimens. Eur. J. Clin. Microbiol. Infect. Dis. 2001, 20, 558–565. [Google Scholar] [CrossRef]
- Perry, J.D.; Ford, M.; Taylor, J.; Jones, A.L.; Freeman, R.; Gould, F.K. ABC medium, a new chromogenic agar for selective isolation of Salmonella spp. J. Clin. Microbiol. 1999, 37, 766–768. [Google Scholar] [CrossRef] [PubMed]
- Schönenbrücher, V.; Mallinson, E.T.; Bülte, M.A. comparison of standard cultural methods for the detection of foodborne Salmonella species including three new chromogenic plating media. Int. J. Food Microbiol. 2008, 123, 61–66. [Google Scholar] [CrossRef] [PubMed]
- Ruiz, J.; Núñez, M.L.; Lorente, I.; Pérez, J.; Simarro, E.; Gómez, J. Performance of six culture media for isolation of Salmonella species from stool samples. Eur. J. Clin. Microbiol. Infect. Dis. 1996, 15, 922–926. [Google Scholar] [CrossRef] [PubMed]
- Ruiz, J.; Nunez, M.L.; Diaz, J.; Lorente, I.; Perez, J.; Gomez, J. Comparison of five plating media for isolation of Salmonella species from human stools. J. Clin. Microbiol. 1996, 34, 686–688. [Google Scholar] [CrossRef] [PubMed]
- Perry, J.D.; Freydière, A.M. The application of chromogenic media in clinical microbiology. Lett. Appl. Microbiol. 2007, 103, 2046–2055. [Google Scholar] [CrossRef] [PubMed]
- Hyatt, D.R.; Weese, J.S. Salmonella Culture: Sampling procedures and laboratory techniques. Vet. Clin. N. Am. Equine Pract. 2004, 20, 577–585. [Google Scholar] [CrossRef]
- Evangelopoulou, G.; Kritas, S.; Govaris, A.; Burriel, A.R. Pork Meat as a Potential Source of Salmonella enterica subsp. arizonae Infection of Man. J. Clin. Microbiol. 2014, 52, 741–744. [Google Scholar] [CrossRef]
- Love, B.C.; Rostagno, M.H. Comparison of Five Culture Methods for Salmonella Isolation from Swine Fecal Samples of Known Infection Status. J. Vet. Diagn. Investig. 2008, 20, 620. [Google Scholar] [CrossRef]
- Davies, P.R.; Turkson, P.K.; Funk, J.A.; Nichols, M.A.; Ladely, S.R.; Fedorka-Cray, P.J. Comparison of methods for isolating Salmonella bacteria from faeces of naturally infected pigs. J. Appl. Microbiol. 2000, 89, 169–177. [Google Scholar] [CrossRef]
- Jensen, A.N.; Sørensen, G.; Baggesen, D.L.; Bødker, R.; Hoorfar, J. Addition of Novobiocin in pre-enrichment step can improve Salmonella culture protocol of modified semisolid Rappaport-Vassiliadis. J. Microbiol. Methods 2003, 55, 249–255. [Google Scholar] [CrossRef]
- Osumi, T.; Asai, T.; Namimatsu, T.; Sato, S.; Yamamoto, K. Enrichment for isolating Salmonella choleraesuis and other Salmonella spp. from pigs. J. Vet. Med. Sci. 2003, 65, 949–951. [Google Scholar] [CrossRef] [PubMed]
- Pangloli, P.; Dje, Y.; Oliver, S.P.; Mathew, A.; Golden, D.A.; Taylor, W.J.; Draughon, F.A. Evaluation of methods for recovery of Salmonella from dairy cattle, poultry, and swine farms. Evaluation of methods for recovery of Salmonella from dairy cattle, poultry, and swine farms. J. Food Prot. 2003, 66, 1987–1995. [Google Scholar] [CrossRef]
- Korsak, N.; Degeye, J.N.; Etienne, G.; China, B.; Daube, G. Comparison offour different methods for Salmonella detection in fecalsamples of porcine origin. J. Food Prot. 2004, 67, 2158–2164. [Google Scholar] [CrossRef] [PubMed]
- Champagne, M.J.; Ravel, A.; Daignault, D. A comparison of sample weight and culture methods for the detection of Salmonella in pig feces. J. Food Prot. 2005, 68, 1073–1076. [Google Scholar] [CrossRef] [PubMed]
- Mejia, W.; Zapata, D.; Mateu, E.; Martin, M. Lack of specificity of a combination of Rappaport-Vassiliadis broth and XLT4 agar for the isolation of salmonellae from pig faeces. Vet. Rec. 2005, 156, 150–151. [Google Scholar] [CrossRef] [PubMed]
- Rostagno, M.H.; Gailey, J.K.; Hurd, H.S.; Mckean, J.D.; Leite, R.C. Culture methods differ on the isolation of Salmonella enterica serotypes from naturally contaminated swine fecal samples. J. Vet. Diagn. Investig. 2005, 17, 80–83. [Google Scholar] [CrossRef] [PubMed]
- De Zutter, L.; De Smedt, J.M.; Abrams, R.; Beckers, H.; Catteau, M.; de Borchgrave, J.; Debevere, J.; Hoekstra, J.; Jonkers, F.; Lenges, J.; et al. Collaborative study on the use of motility enrichment on modified semisolid Rappaport-Vassiliadis medium for the detection of Salmonella from foods. Int. J. Food Microbiol. 1991, 13, 11–20. [Google Scholar] [CrossRef]
- Bauwens, L.; Vercammen, F.; Bertrand, S.; Collard, J.M.; De Ceuster, S. Isolation of Salmonella from environmental samples collected in the reptile department of Antwerp Zoo using different selective methods. J. Appl. Microbiol. 2006, 101, 284–289. [Google Scholar] [CrossRef]
- Koyuncu, S.; Haggblom, P. A comparative study of cultural methods for the detection of Salmonella in feed and feed ingredients. BMC Vet. Res. 2009, 5, 6. [Google Scholar] [CrossRef]
- Ewing, W.H. Differentiation of Enterobacteriaceae by biochemical reactions. In Edwards and Ewing’s Identification of the Enterobacteriaceae, 4th ed.; Elsevier Science Publishing Co., Inc.: New York, NY, USA, 1986; pp. 47–72. [Google Scholar]
- Falcao, D.P.; Trabulsi, L.R.; Hickman, F.; Farner, J.S. Unusual Enterobacteriaceae: Lactosepositive Salmonella typhimurium which is endemicin Sao-Paulo, Brazil. J. Clin. Microbiol. 1975, 2, 349–353. [Google Scholar] [CrossRef]
- Rokey, N.W.; Mecca, M.D. Lactose fermenting salmonellae—A dilemma for diagnostic laboratories? Proc. Annu. Meet. U.S. Anim. Health Assoc. 1972, 75, 509–514. [Google Scholar]
- Blackburn, B.O.; Ellis, E.M. Lactose-fermenting Salmonella from dried milk and milk-drying plants. Appl. Microbiol. 1973, 26, 672–674. [Google Scholar] [CrossRef] [PubMed]
- Johnston, K.G.; Jones, R.T. Salmonellosis in calves due to lactose fermenting Salmonella typhimurium. Vet. Rec. 1976, 98, 276–278. [Google Scholar] [CrossRef]
- MacDonald, C.; Riley, M. Cloning chromosomal lac genes of Klebsiella pneumoniae. Gene 1983, 24, 341–345. [Google Scholar] [CrossRef] [PubMed]
- McDonough, P.L.; Shin, S.J.; Lein, D.H. Diagnostic and Public Health Dilemma of Lactose-Fermenting Salmonella enterica Serotype Typhimurium in Cattle in the Northeastern United States. J. Clin. Microbiol. 2000, 38, 1221. [Google Scholar] [CrossRef] [PubMed]
- Barrett, E.L.; Clark, M.A. Tetrathionate Reduction and Production of Hydrogen Sulfide from Thiosulfate. Microbiol. Rev. 1987, 51, 192–205. [Google Scholar] [CrossRef]
- Ewing, W.H. Edwards and Ewing’s Identification of Enterobacteriaceae, 4th ed.; Elsevier: Amsterdam, The Netherlands, 1985; p. 192. [Google Scholar]
- Lannigan, R.; Hussain, Z. Wound Isolate of Salmonella typhimurium That Became Chlorate Resistant after Exposure to Dakin’s Solution: Concomitant Loss of Hydrogen Sulfide Production, Gas Production, and Nitrate Reduction. J. Clin. Microbiol. 1993, 31, 2497. [Google Scholar] [CrossRef]
- Sasahara, K.C.; Heinzinger, N.K.; Barrett, E.L. Hydrogen Sulfide Production and Fermentative Gas Production by Salmonella yphimurium Require F0F1 ATP Synthase Activity. J. Bacteriol. 1997, 179, 6736–6740. [Google Scholar] [CrossRef]
- Clarke, P.H. Hydrogen Sulphide Production by Bacteria. J. Gen. Microbiol. 1953, 8, 397407. [Google Scholar] [CrossRef]
- Leinweber, F.J.; Monty, K.J. The metabolism of thiosulphate in Salmonella typhimurium. J. Biol. Chem. 1963, 238, 3775–3780. [Google Scholar] [CrossRef]
- Rambach, A. New plate medium for facilitated differentiation of Salmonella spp. from Proteus spp. and other enteric bacteria. Appl. Environ. Microbiol. 1990, 56, 301–303. [Google Scholar] [CrossRef] [PubMed]
- Burkardt, H.J.; Mattes, R.; Schmid, K.; Schmitt, R. Properties of two conjugative plasmids mediating tetracyclineresistance, raffinose catabolism, and hydrogen sulfide production by Escherichia coli. Mol. Gen. Genet. 1978, 166, 75–84. [Google Scholar] [CrossRef] [PubMed]
- Lautrop, H.; Orskov, I.; Gaarslev, K. Hydrogensulphide producing variants of Escherichia coli. Acta Pathol. Microbiol. Scand. 1971, 79, 641–650. [Google Scholar] [CrossRef] [PubMed]
- Layne, P.; Hu, A.S.L.; Balows, A.; Davis, B.R. Extrachromosomal nature of hydrogen sulfide productionin Escherichia coli. J. Bacteriol. 1971, 106, 1029–1030. [Google Scholar] [CrossRef] [PubMed]
- Magalhies, M.; Veras, A. Properties of pPE1572(Hys-Raf), a plasmid governing hydrogen sulphide production and raffinose fermentation in Escherichia coli. J. Gen. Microbiol. 1977, 99, 445–447. [Google Scholar] [CrossRef] [PubMed]
- Orskov, I.; Orskov, F. Plasmid-determined H2S character in Escherichia coli and its relation to plasmid-carried raffinose fermentation and tetracycline resistance characters. Examination of 32 H2S-positive strains isolated during theyears 1950–1971. J. Gen. Microbiol. 1973, 77, 487–499. [Google Scholar] [CrossRef] [PubMed]
- Bulmash, J.M.; Fulton, M.; Jiran, J. Lactose and sulfide reactions of an aberrant Salmonella strain. J. Bacteriol. 1965, 89, 259. [Google Scholar] [CrossRef]
- Barbour, E.K.; Nabbut, N.H.; Al-Nakhli, H.M. Production of H2S by Escherichia coli isolated from poultry: An unusual character useful for epidemiology of colisepticemia. Avian Dis. 1985, 29, 341–346. [Google Scholar] [CrossRef]
- Darland, G.; Davis, B.R. Biochemical and serological characterization of hydrogen sulfide-positive variants of Escherichia coli. Appl. Microbiol. 1974, 27, 54–58. [Google Scholar] [CrossRef]
- Maker, M.D.; Washington, J.A.I.I. Hydrogensulfide-producing variants of Escherichia coli. Appl. Microbiol. 1974, 28, 303–305. [Google Scholar] [CrossRef]
- Carrique-Mas, J.J.; Davies, R.H. Sampling and bacteriological detection of Salmonella in poultry and poultry premises: A review. Rev. Sci. Tech. Off. Int. Epiz. 2008, 27, 665–677. [Google Scholar] [CrossRef] [PubMed]
Disclaimer/Publisher’s Note: The statements, opinions and data contained in all publications are solely those of the individual author(s) and contributor(s) and not of MDPI and/or the editor(s). MDPI and/or the editor(s) disclaim responsibility for any injury to people or property resulting from any ideas, methods, instructions or products referred to in the content. |
© 2024 by the authors. Licensee MDPI, Basel, Switzerland. This article is an open access article distributed under the terms and conditions of the Creative Commons Attribution (CC BY) license (https://creativecommons.org/licenses/by/4.0/).